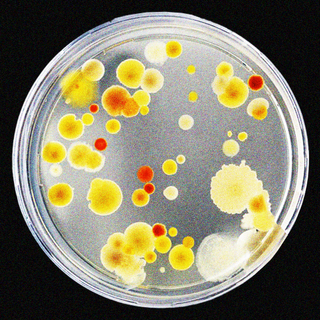

How Being Guilt‑Tripped by Parents, Partners Can Leave Long‑Term Mental Scars
“Guilt is a powerful emotion and can therefore be a powerful tool of manipulation… [It] interferes with our decision-making processes.”

“We’re getting old — what do you mean you’ll fly back home after three months? I dedicated my life to bringing you up… but you can’t even be bothered to visit more often?”
“I can’t believe you have to work late again. It’s like you don’t want to spend time with me at all. Can you imagine how that makes me feel?”
“What do you mean you can’t make it to brunch? Ever since you got married, you don’t care about girls’ time at all… Why do I even bother!”
If you’ve been subjected to similar guilt-inducing statements from parents, partners, or even friends, you probably know the feeling it leaves you with — one of unease and self-hate for not being a good offspring, partner, or friend, and naturally, of guilt. If you have been guilt-tripped, you know how well those feelings serve to compel you into doing something you may not otherwise have.
“Guilt is a powerful emotion and can therefore be a powerful tool of manipulation. Guilt-tripping is an indirect form of communication that uses shaming or blaming someone with the purpose of convincing them to comply with a request… Guilt interferes with our decision-making processes and causes us to engage in actions or refrain from actions in a different way than we normally would,” says Leah Porritt, a behavior specialist.
In the long-term, however, being manipulated thus can become a slow and silent killer of relationships. Yet, people continue to employ the tactic because it can have an immediate payoff — as compared to requesting something, using guilt is a quick, sure shot way to get people to do your bidding.
People also guilt-trip to establish — or, in many cases, maintain — power dynamics in relationships. Describing her relationship with her ex-boyfriend, Hiral, 29, says, “Whenever we fought, he kept expecting me to make up to him.” By guilting her for one thing or another – even for “picking a fight” with him when all she did was “call him out” for lying to her about gambling and drug-use – he managed to get her to apologize for no fault of hers.
Related on The Swaddle:
Indian Adults Are Leading ‘Double Lives’ to Avoid Controlling Parents. But What’s the Hidden Cost?
But as Sarah Epstein, a marriage and family therapist, explains, the “short-term win” is simply setting one up for “long-term loss.”
My parents’ guilt-tripping throughout my childhood – and their attempts to do so well into my adulthood – ultimately created a gaping crack in our relationship too. I gradually began to distance myself from them — albeit subconsciously — when the constant negativity became too much. “Guilt erodes a relationship and creates resentment… An adult child who feels manipulated into contact, who feels compliant rather than excited to show up, may remain emotionally absent,” Epstein notes.
“It was mentally draining and I felt exhausted… We eventually broke up,” says Gayathri, 23, who experienced guilt-tripping in an intimate relationship.
Unfortunately, however, that’s not where the impact of guilt-tripping ends. Prolonged guilt-tripping may lead us to distance ourselves from our manipulators over time. But it doesn’t make the guilt disappear – especially since we internalize it over time. It may be relatively simpler to shake off guilt strangers may try to trip us with. But when it comes from people we love and trust, the guilt becomes a part of us.
N., 29, who was made to “feel like a loser” by his ex-girlfriend, says that even after the relationship was over, “If anything went wrong in my life, or [even] in the lives of people around me, I felt guilty for being the ‘bad part of their lives’… even though they may have never said anything to suggest that even remotely.”
Gayathri says her relationship damaged her self-confidence so much that she lost the ability to take stands for things she believed in, or call other people out for being bigoted. “[When] I hear my male friends make sexist jokes, or say inappropriate things, I am tongue-tied… The fear of losing people holds me back,” she says. Not only that, despite breaking up with her boyfriend, she’s still haunted by the idea that, maybe, “that’s what guys are like, and I lost him because of my overthinking.”
Being subjected to guilt — especially in close relationships that involve people we trust — can also impact our long-term mental health. Porritt says being subjected to prolonged guilt-tripping can lead to depression, anxiety, and paranoia. Perhaps, it is one of the factors that led me to a psychiatrist’s office at 15 and resulted in my prescription for anti-depressants at such young age. What I do know is that even at 26, someone I was dating pointed out to me how guilt steered most of my actions, and how easily friends and colleagues could manipulate me into doing things I didn’t want to — simply by guilting me.
Related on The Swaddle:
Many Indian Families Express Care Through ‘Bullying,’ Creating Patterns of Abuse
The long-term self-hatred that long-term guilt trips beget, also makes people more prone to abuse in future relationships. Since survivors of such manipulation are convinced they’re “not worthy,” they start believing anyone who chooses to love, trust, or even employ them, is doing them a favor — leading them to never protest when their boundaries begin to be violated.
Three years after breaking up with her ex, Hiral began dating another man who treated her in much the same way. Why did she put up with it? “I was convinced no one in their right mind would be in a relationship with me,” she says.
Srishti, 28, was briefly engaged to a man who guilt-tripped her on a regular basis. She explained the abuse to her parents and broke off her engagement. But she continued to feel “imperfect and flawed.” In fact, “I would assume being bullied into situations was normal, being ignored and disrespected was okay,” she says, adding that it led her to a situation where she felt guilty for refusing him when her “office crush” tried to touch her without her consent. “I slapped him… he screamed and slapped me back… and somehow, I felt I deserved it,” she says.
Fortunately for Srishti, she was gradually able to pull herself out of the toxic cycle, and even report her erstwhile crush to their HR.
But when guilt-tripping is used as a parenting strategy, it’s less easy to even cut all ties and move on — especially given that we live in a culture, where we’re taught to worship our parents, and consume movies like Baghban (2003) and Kabhi Khushi Kabhie Gham (2001) that serve to further reinforce the guilt.
Unfortunately, being constantly guilt-tripped in our formative years, leads us to depend on external validation to determine our self-worth. “[It] teach[es] our kids to search for outward validation rather than internal validation; it teaches them to look to the responses of others to determine whether they — and their actions — are good or bad,” explains Lorie Kaufman, a professional clinical counselor.
Being caught in that web can hold people back from being themselves — keeping them from self-actualization.
Devrupa Rakshit is an Associate Editor at The Swaddle. She is a lawyer by education, a poet by accident, a painter by shaukh, and autistic by birth. You can find her on Instagram @devruparakshit.
Related

Work Harassment, Sexual Assault Linked to High Blood Pressure in Women: Study
